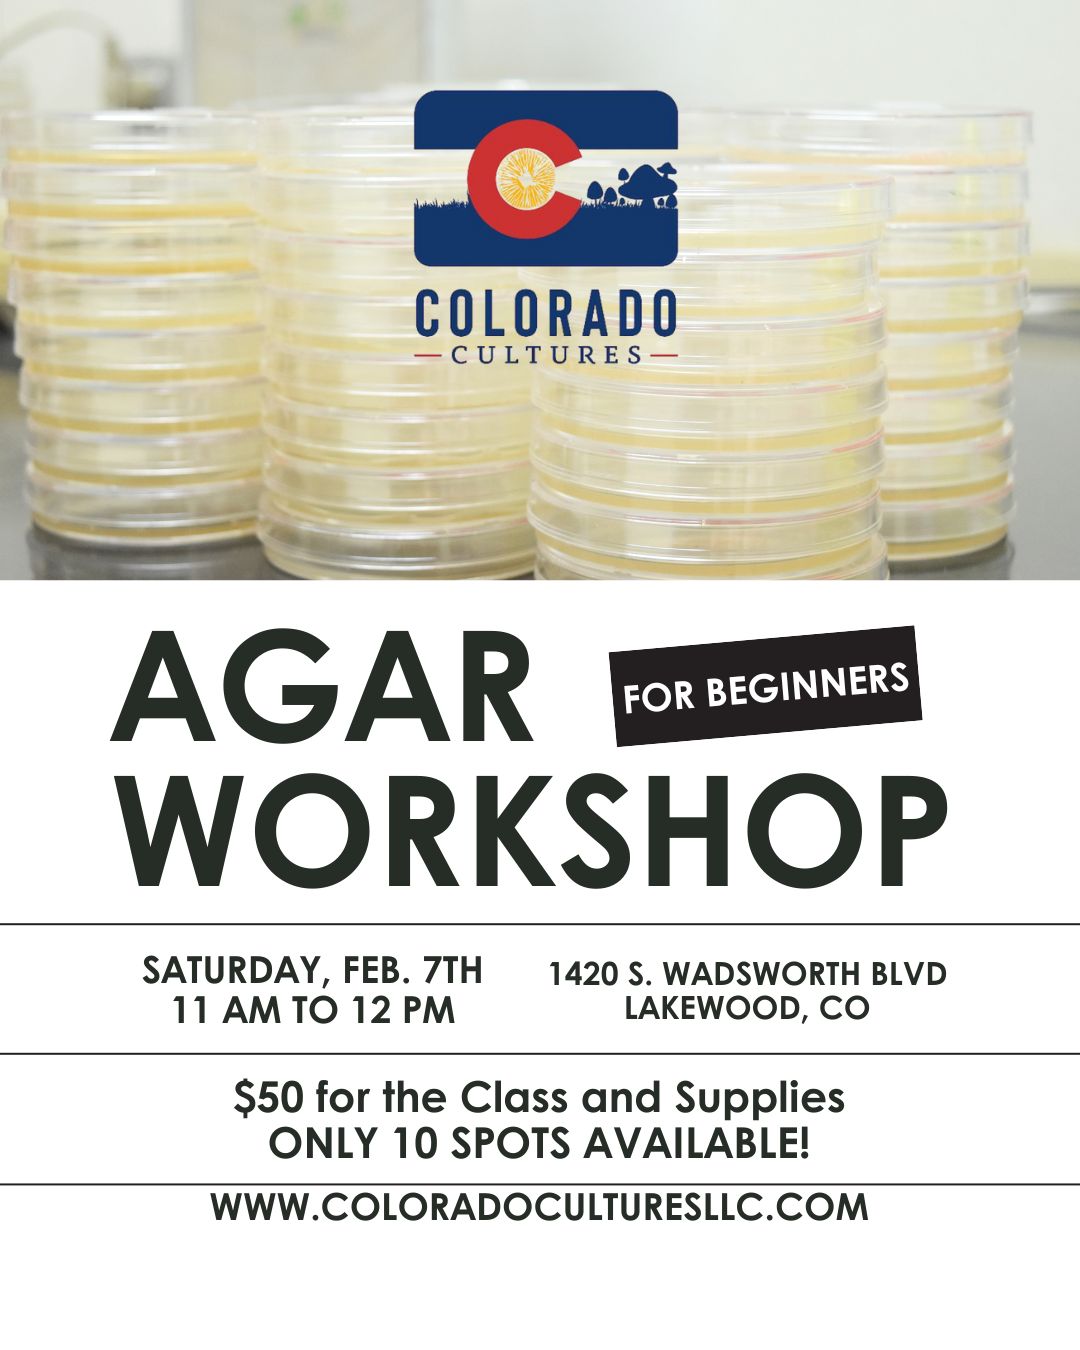
Agar Workshop for Beginners

This is a small, intimate class with only 10 spots available, ensuring plenty of one-on-one guidance and time for questions.
Class Details:
- 📅 Date: February 7th
- ⏰ Time: 11:00 AM
- 📍 Location: CC Classroom
- 💲 Cost: $50 per person
- 👥 Limited to 10 students
What’s Included:
- Your own desk seat in the classroom
- Coffee and drinks to enjoy
- Pre-colonized agar plate featuring an easy to work with high-quality genetic
- 5-pack of agar dishes to use during class and take home
- Sterile scalpel
- Isopropyl alcohol
- Parafilm strips to properly seal your plates
You’ll learn the basics of agar work with our lead Mycologist Brian, including clean handling techniques, transfers, and how to continue practicing at home with confidence. Whether you’re brand new to agar or looking to sharpen your skills, this workshop is a perfect starting point.
Spots are limited and will fill quickly — reserve yours early!